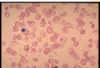

Red Blood Cells Flashcards
Where do all blood cells originate from
Bone marrow
Where are the blood cells derived from
Haemopoietic stem cells
What gives rise to erythrocytes
Myeloid stem cells
Table of the blood cells

What are the HSC characteristics
Self-renew (daughter cells remain as HSC)
Differentiate to daughter cells
Stem cell hierarchy

Where are HSC developed in fetus
3 wks in the mesoderm (yolk salk)
6-8 wks liver takes over and remains principal until shortly before birth
10 wks bone marrow
Where is HSC developed in children
Bone marrow everywhere
Where is HSC developed in adults
Pelvis, femur, sterum and proximal arm and thigh
Other sites may retain their ability
Haemopoiesis may occur outside the bone marrow
What is haemopoiesis regulated by
Genes, transcription factors, growth factors and microenvironment
What are haemopoietic growth factors
Glycoprotein hormones which bind to cell surface receptors
Regulates proliferation and differentiation of HSC
Regulate function of mature blood cells
What is the role of erythropoietin
Induces erythropoiesis
Synthesised in the kidney
Glycoprotein
Stimulates bone marrow to produce more red blood cells
Direct cause or reduced oxygen to the kidney
How are granulocytes and monocytes regulated
G-CSF
Granulacyte Macrophage Colony Stimulating Factors
Cytokines e.g. interleukins
What is the role of thromopoietin
Platelet production
Megakaryocytopiesis
Produced by cells of the bone marrow
Development of red blood cells

Why do we need iron
Oxygen transport in haemoglobin
DNA synthesis
Mitchondrial proteins
Where is haem iron (Fe2) found
Red meat
Fish
Where is non-haem iron found
Grains
Beans
Plant based food
Dairy
Nuts
Soya beans - contains phytates which reduce iron absorption
What reducing substances are required to absorb non-haem iron
Ascorbic acid
Vitamin C
Why is it important to regulate iron absorption
Iron can form free radicals which can damage tissues
What is the molecule that transports iron
Transferrin
What is hepcidin
Regulates absorption of iron
Ferroportin - Fe3
Ferritin - Fe2
Iron is shed into the gut lumen otherwise

What cytokines are produced in inflammatory response
IFNy - reduction in erythropoiesis
IL-1 TNFa and IL-6 mediate hepcidin
How does hepcidin cause anaemia?
Prevent uptake of iron
What is folate/folic acid and B12 used for
Synthesis of Thymine
Inhibits DNA synthesis
What does the deficiency of Vitamin B12 and folate affect
Rapidly dividing cells
Bone marrow - cells can grow but cannot divide (megablastic erythropoesis)
Epithelial surfaces of mouth and gut
Gonads
Sources of B12
Meat
Liver and Kidney
Fish
Oyster and clams
Eggs
Milk and cheese
Folic acid
Green leafy vegetables
Cauliflower
Brussels sprout
Live and kidney
Whole grain cereals
Yeast
Fruit
How is B12 absorped
Cleaved by HCl in stomach
Binds to intrinsic factor
Binds to receptors in the ileum
Vitamin B12 deficiency
Inadequate intake
Lack of acid in stotmach
Inadequate secretion of IF
Malabsorption
When do folic acid requirements increase
Pregnancy
Increased red cell production
How are red blood cells destroyed
Phagocytic cells of the spleen
Haem Bulirubin is excreted in bile
What does erthrocyte function depend on
Integrity of the membrane
Haemoglobin structure
Cellular metabolism
Why are erythrocytes binconcave
Help them maneouver
Made up of a lipid bilayer supported by cytoskeleton and transmembrane proteins
Maintain integrity and elasticity
What is hereditary spherocytosis
Disruption of vertical linkages in membrane
Spherocytes
Loss of cell membrane without loss of cytoplasm
Red cells become less flexible and undergo haemolysis
What is hereditary elliptocytosis
Disruption of horizontal linkages
Elliptocytes - occurs in iron deficiency as well
What is haemoglobin made up of
2 a and 2 b globin chain bound to a haem group
Each haem group consists of ferrous iron held in a ring known as porphyrin
At birth it is 2 a and 2 y chains
What is the type of haemoglobin in foetus
Haemoglobin F
Bohr shift

How are RBC highly adapted
Generation of ATP
maintenance of haemoglobin function, membrane integrity and RBC volume
Glucose-6-phosphate dehydrogenase
Can cause intermittent severe intravascular haemolysis as a result of infection or exposure to oxidant
Normally hemizygous males as X linked
May be food
Distribution parallels malaria, selective advantage
Picture of G6PD
Irregularly contracted cell
Loss central pallor
Hemighost because of loss of cell membrane
Oxidant damage
Heinz bodies found

Size of red blood cells

Causes of microcytosis
Iron deficiency
Anaemia of chronic disease
Defect in globin synthesis (thalassaemia)
Different types of macrocytes
Round
Oval
Polychromatic

Causes of macrocytosis
Lack of vitamin B12 or folic acid (megaloblastic anaemia)
Liver disease and ethanol toxicity
Haemolysis (polychromasia)
Pregnancy
What is the colour of RBC
1/3 is pale due to lack of haemoglobin
What is hypochromia
Cells have a larger central pallor
Lower haemoglobin content
Hympochromia and microcytosis often go together
Polychromasia
Increased blue tinge
Cell is young
What does new methylene blue stain do
Stain higher RNA content in reticulocytes
When does reticulocytosis happen
Response to bleeding
Red cell destruction
Anisocytosis
Variation in size than normal
Poikilocytosis
Variation in shape of red blood cells
What are target cells
Accumulation of haemglobin in central pallor
Can occur in obstructive jaudice
Liver disease
Haemoglobinopathies
Hyposplenism
Why does sickle cell have that shape
Haemoglobin S happens where the are one or two copies of an abnormal B globin gene
Haemoglobin S is less soluble than Haemoglobin A
Chartrge glutamic acid replaces by an uncharged valine molecule
What are red cell fragments
Schistocytes
Shearing process caused by platelet rich blood clots
Reference range
Carefully defined reference range
How to interpret blood count
Anaemia?
Blood count?
Clinical history?


